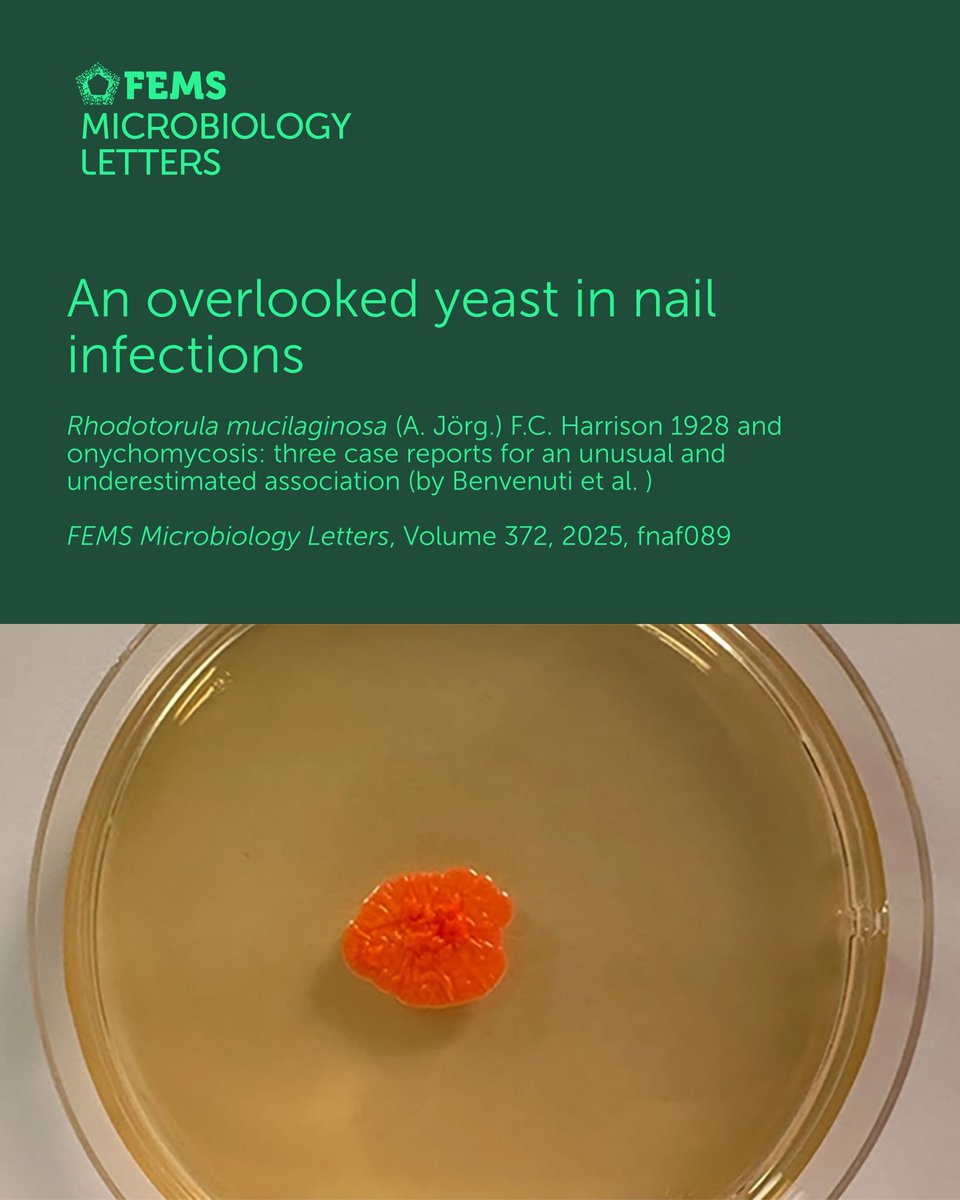
FEMS tweet media

FEMS
15.5K posts

FEMS
@FEMSmicro
Federation of European Microbiological Societies | Publish with purpose in the not-for-profit #FEMSJournals | #microbiology | https://t.co/8oBtPs3tTm
Katılım Şubat 2010
2.1K Takip Edilen22.3K Takipçiler

Check-out the latest advances in Microbial C1 Metabolism: L Larke-Mejía et al. studied the structural and evolutionary insights into the isoprene monooxygenases.
buff.ly/bTdHlvO
#FEMSMicrobiolEcol #ecology

English

Every microbiologist knows the profound impact microbes have on everyday living. The challenge is how to make that knowledge accessible so it can benefit health, public policy & the environment. This thematic issue brings together practical approaches: buff.ly/QjA4y8s

English

Open access is an important step forward for science. We also recognise that not every researcher has access to APC funding. FEMS Microbiology Letters ensures researchers across our community can share their work in a not-for-profit FEMS journal ➡️ buff.ly/G58iJ52

English

AM fungi underpin terrestrial ecosystems, yet their global patterns remain unclear. Stewart et al. show >70% of ecoregions lack soil metabarcoding data, highlighting key sampling gaps. Read the 2025 FEMS Microbiology Letters Article Award winner 🏆buff.ly/Rw3Cbkt

English

As the antimicrobial resistance on the rise, scientists are shaking up a new kind of mix, #phage cocktails! Kaneko et al. discuss the latest technologies and strategies for designing effective phage cocktails.
#FEMSMicrobiolRev
buff.ly/on2VDAb

English

Stay ahead in what's happening in microbiology research and in the FEMS journals.
The FEMS Journals newsletter brings you novel science, grant and collaboration opportunities, and useful resources that will support your publishing journey. Sign up: buff.ly/A0469Vm.

English
FEMS retweetledi

For decades we tried to explain #esca with Koch’s postulates. What if that framework is simply not enough?
Our new review in @FEMSmicro proposes esca as a stress-mediated pathobiome disorder of the #grapevine holobiont doi.org/10.1093/femsec… #microbiome


English
FEMS retweetledi

Crystal structure of methanogen MtxX (Methanogen Marker Protein MMP4) from Methanothermobacter thermautotrophicus ΔH
#microbiology #methanogens #methane
@FEMSmicro
doi.org/10.1093/femsmc…


Plasmids don’t always get the spotlight in Helicobacter pylori research, but they might matter more than we think. In this new FEMS Microbiology Letters study, the authors mapped the H. pylori plasmidome and identified high-confidence plasmid sequences buff.ly/hU0pQcL

English

Many research projects produce sound findings that never become full papers. FEMS Microbiology Letters publishes focused microbiology studies, so valuable findings can reach the research community, however small. Learn more: buff.ly/G58iJ52

English

FEMS Microbiology Letters publishes excellent, short research with robust insights. Here are a few papers that help understand the real-world impact of microbial influences with clear take-home messages: buff.ly/0O6hQOh

English

Check-out FEMS Microbiology Ecology Latest Editor's Choice: Wutkowska et al. uncovered hidden phylo- and ecogenomic diversity of the widespread methanotrophic genus Methylobacter
buff.ly/J2WX6PE
#FEMSMicrobiolEcol #ecology

English

The FEMS journals are not about profit margins but about the community they serve. For over 50 years, our goal has been to advance research microbiology research & connect scientists worldwide. Join the movement, publish for & with the community: buff.ly/CzUwj7l

English

Microbes grow in spatially structured communities. Bäcker et al. comprehensively synthesize evidence that spatial organization drives microbial ecological and evolutionary processes across scales. #FEMSMicrobiolRev buff.ly/wceLoPr @bramvandijk.bsky.social

English

Methane is the second most abundant greenhouse gas with a high heat-trapping capacity but a short lifespan in the atmosphere.
So-called “microbial methane munchers” can lower methane emissions from diverse ecosystems, as explored on #FEMSmicroBlog.
buff.ly/xrtJxBi

English

How do thiol groups help #Saccharomyces_cerevisiae overcome acetic acid stress? 🍷🧬
Explore how A. Shirvanyan et al. link redox balance, metabolism & pH to improved tolerance in wine and beer strains:
🔗 buff.ly/GGeI24A
#FEMSYeastRes

English

Happy #IWD2026 to our community and to everyone working to advance microbiology.
To mark the day, we are sharing reflections from across our community on the FEMS blog: buff.ly/FQSm3iS
Thank you to all the women in microbiology for the impact you make every day.

English

Lhoste et al. determined that seasonal variation and depth structure microbial communities in a stratified mining lake, highlighting their key roles in carbon and sulfur cycling within an artificial aquatic ecosystem.
buff.ly/itFlhRv
#FEMSMicrobiolEcol #ecology

English

As a brilliant scientist & advocate for rigorous microbiology research, Prof. Jeff Cole was committed to advancing the field & supporting the growth of young scientists. His legacy will continue to shape the community he helped nurture with such passion: buff.ly/xgTou3Y

English